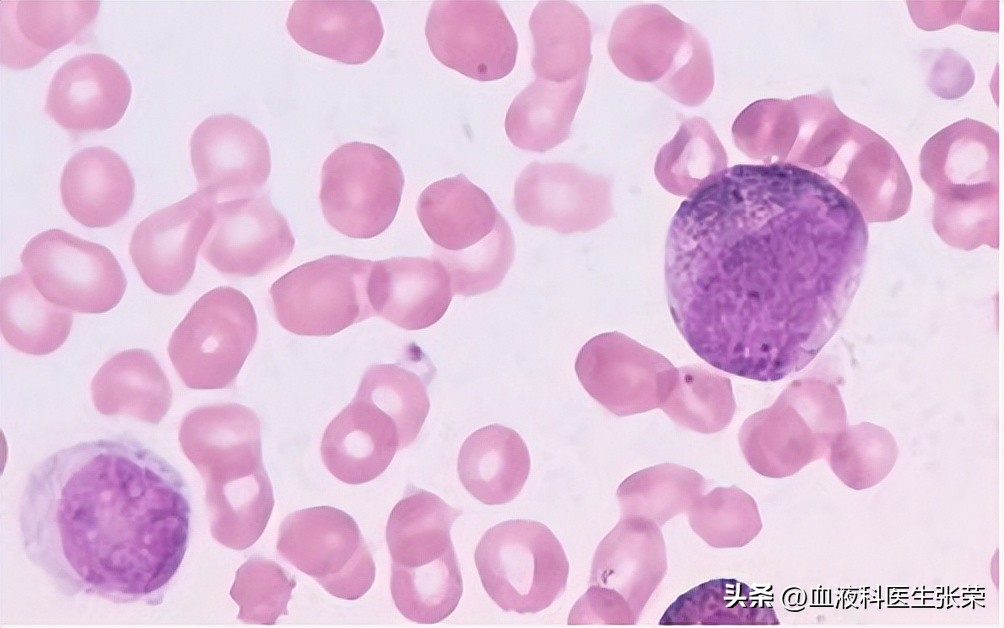
再障血小板低怎么才能升上去,再障患者血小板不长怎么办

三系血细胞减少是再障的典型症状,易引发贫血、出血、感染等并发症,对患者生命造成威胁,因此,再障患者会格外关注三系血细胞的上升情况。但也总有再障患者咨询:经过一段时间治疗,血红蛋白数值、白细胞数值都已经恢复稳定了,可是血小板却迟迟升不上去,为什么?该怎么办?如何提升血小板?
血小板迟迟升不上去及血小板增长缓慢是导致再障病程过长的主要原因之一,因此,再障患者想要更快康复,稳定提升血小板迫在眉睫。
治疗再障后,为什么血小板数值迟迟升不上去?
与再障骨髓造血功能的恢复规律及治疗效果有关!三系血象全面恢复是再障治疗的最终目标,但是血象恢复并不同步。不管再障发病原因是什么,不管病情轻重急慢,再障患者骨髓造血功能的恢复规律是不变的,一旦造血功能受损,均按照血红蛋白(Hb)→白细胞(WBC)→血小板(PLT)的恢复模式进行造血组织的修复,这是血小板提升较慢的原因之一,当然治疗效果的好坏也占重要因素。医生和患者必须遵循这一规律,治疗过程中切不可心急。
血小板迟迟升不上去,该怎么办?再障患者做到这2点,稳定提升血小板!

①骨髓造血功能的恢复与重建,需要再障患者坚持治疗,不放弃!
再障患者骨髓造血功能恢复与重建需较长时间及疗程,有的患者需要半年、有患者需要在一年,具体疗程要根据患者个人病情及体质而定。疗程不到,切勿频繁换药或放弃治疗。
②中西医联合治疗,取长补短,优势互补,恢复骨髓造血!
西药的特点:疗效启动相对较快,但副作用较大,有的药物或疗法价格昂贵。对于急重型再障患者,西药治疗不可缺少。
中药的特点:疗效启动较慢,一旦见效,疗效较巩固持久,副作用低微。适合于慢性再障患者。
总结:中西医结合治疗能够互相取长补短,发挥优势互补作用,可提高有效率及疗效程度,恢复骨髓自身造血功能。